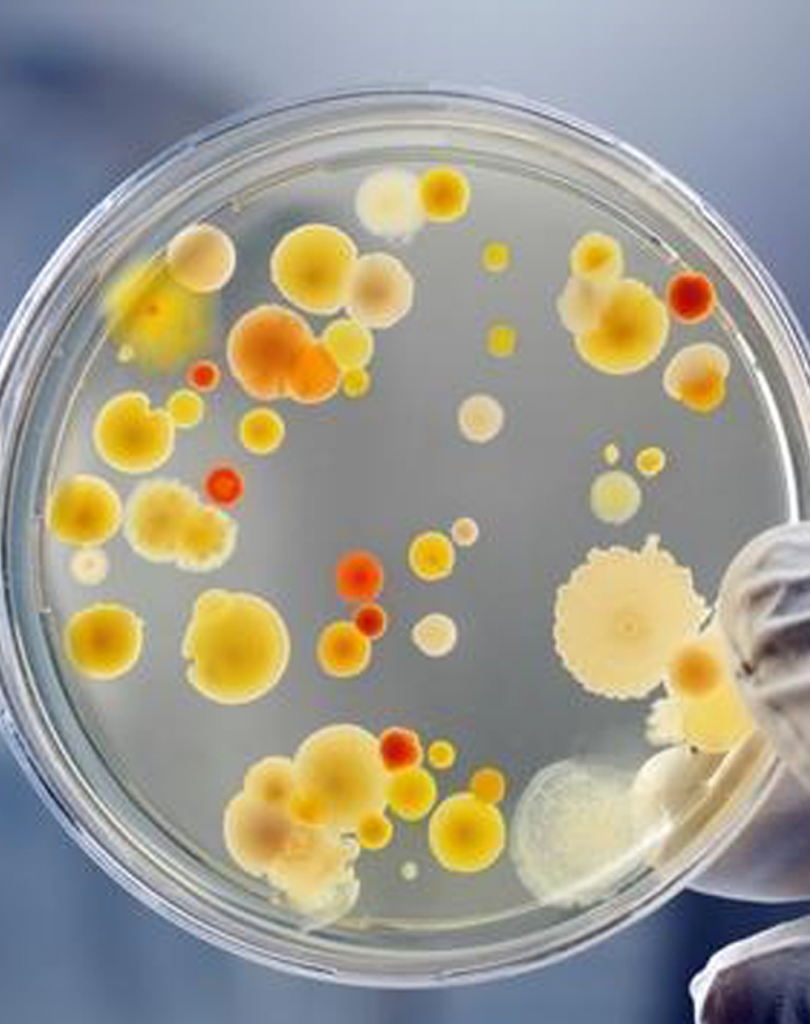
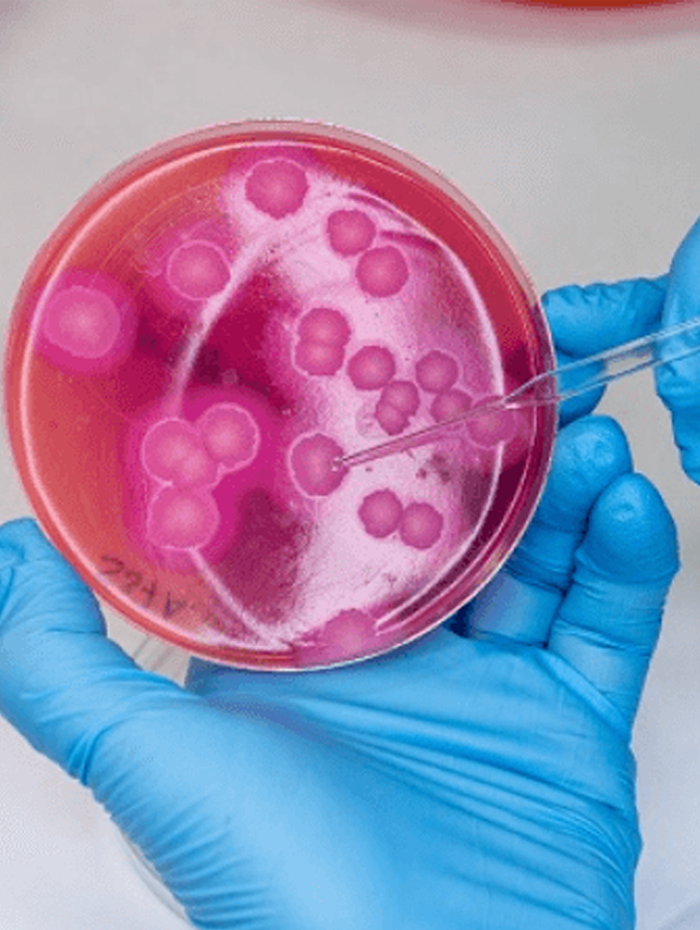
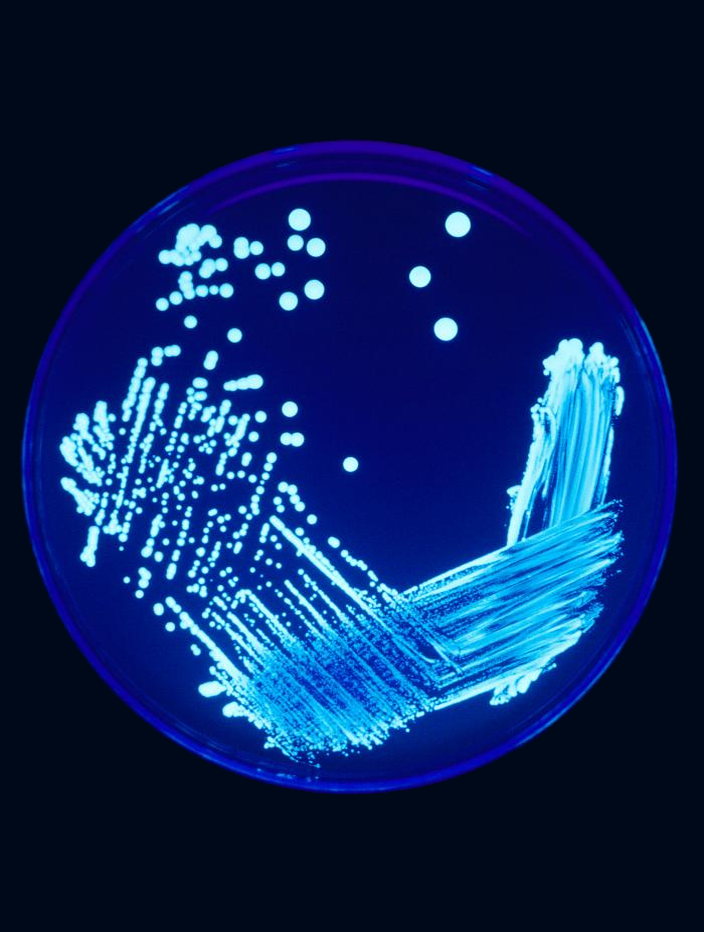
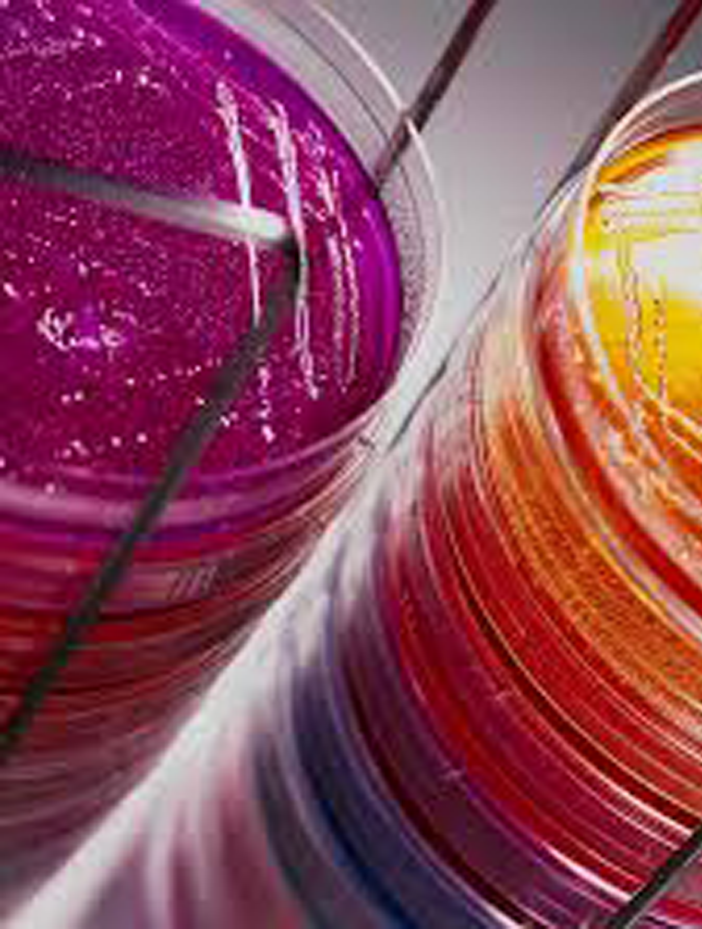

We're a fully accredited microbiology testing laboratory
Our Areas Of Expertise
Our main specialty is Microbiology. Tap with 32 years of working experience on all microbiological techniques applicable in different industry, ranging from most sophisticated pharmaceutical industry to ancient raw material manufacturing industry.
IM labs is a full-service microbiology consulting service, providing a broad range of expert services. Consulting services include but are not limited to method development and validation, wastewater treatment, industrial contamination, indoor air quality, technical training and technology assessment.
IM labs can provide customized microbiology workshops in all areas including microbial load assessment of materials, Bio-Assay, Sterility testing, Isolation & Identification of organisms, Environmental Monitoring, sampling and culture techniques, basic laboratory safety, anaerobic growth techniques, or any specific protocol or requirement.
We offer a laboratory management and training program for onsite microbiology laboratories staffed only with technician for far less than the cost of hiring a full time microbiologist to run your microbiology lab.
IM labs can provide this level of expertise on an occasional or as-needed basis, to keep your technicians well-trained and up-to-date. We can be available whenever a crisis or a question arises, so that you and your staff can feel secure in knowing that we are only a phone call away.
Microbiological Sampling
Representative Sample and sampling technique play a major role in the out come of analytical procedure. Sampling technique play a very critical role when microbiological sapling is carried out. It includes all kind of sampling such as materials, products, swabbing, environmental, water, personnel monitoring and cleaning validation so on so forth. Most of the time wrong sampling technique results in misleading data. Hence, uncertainty about the quality of products, wastage of resources and delays in product release. Other part which contributes the most is the training of a person doing sampling. We design sampling plans to meet the needs of your study and to fit your budget and train your staff for right techniques of sampling.


Microbiologist for Industries & Techniques
In microbiology automation is not as much of chemical laboratory. Majority of microbiological assessment are done manually or at least at some stage manual handling can not be avoided. As a consequence microbiologist part becomes more important. According to the nature of industry, microbiologist training and techniques need to be developed, validate and implement with regular follow up and review.
Development of Microbiological Procedures & Validation
We offer full service from method development, validation, implementation, and training of your microbiologist and follow up visit to review and rectify any come across problem during routine use.
For pharmaceutical industry, we are specialist in Bio-Assay, Sterility Test and LAL test.

Environmental Monitoring
Airborne biological agents, such as bacteria and mold can cause serious manufacturing problems. IM labscan help in the assessment and remediation of airborne biological agents. We can conduct a complete and thorough microbial investigation. We follow FDA guidelines and use only accredited laboratories for sample identification. We then interpret the laboratory results into a simple, clear and useful explanation of the relationship between the contaminating microbes and their effects on product quality
Microbiology Lab Set-up
IM labs has special interest to develop your microbiology lab according to your requirements and applicable regulatory requirements if any.
Service includes:
Preliminary evaluation of proposed area and its suitability for the purpose
Preparation of lay out
Selection of materials, equipment, furniture and services
Preparation of feasibility report
Development of documentations system
Supervision during development
Validation
Start-Up and Trial testing
Training of staff
Follow-Up Assessment and submission of completion Report

Microbiology Lab Enhancement
Weather your microbiology lab needs expansion due to changing business needs or you desire bring up to date your microbiology lab. IMlabs will take care all
Service includes:
Assessment of your micro lab
Preparation of Inspection Report and action plan.
Discussion and agreement of action plan
Selection of materials, equipment, furniture and services
Preparation of feasibility report
Supervision during Implementation of action plan
Validation
Start-Up and Trial testing
Training of staff
Follow-Up Assessment and submission of completion Report
Microbiological Assessment of your Facility & Control of Contaminants
Any industrial process that provides a moist environment allows for the growth of microbes. Bacteria and mold can cause fouling and deterioration of wood, metal and plastic pipes and equipment. Contamination of solutions and processes can destroy valuable products or reagents.
IM labs applies the basic principles of microbial ecology to diagnose and correct or prevent damage to industrial processes by contaminating microbes. We will identify the culprits and recommend solutions for treatment and prevention of contamination that are compatible with your industrial process.

Disposal of Microbiological Wastes
Waste from microbiology lab is a potential hazardous to your personnel, lab, facility and as well as to the environment. If it is not decontaminated properly it may ends up in your systems and poses a potential threat to your facility.
If you have a problem that may involve microbiology, we are happy to discuss it with you and may be able to provide a solution. We pride ourselves on our reputation for integrity and client satisfaction
